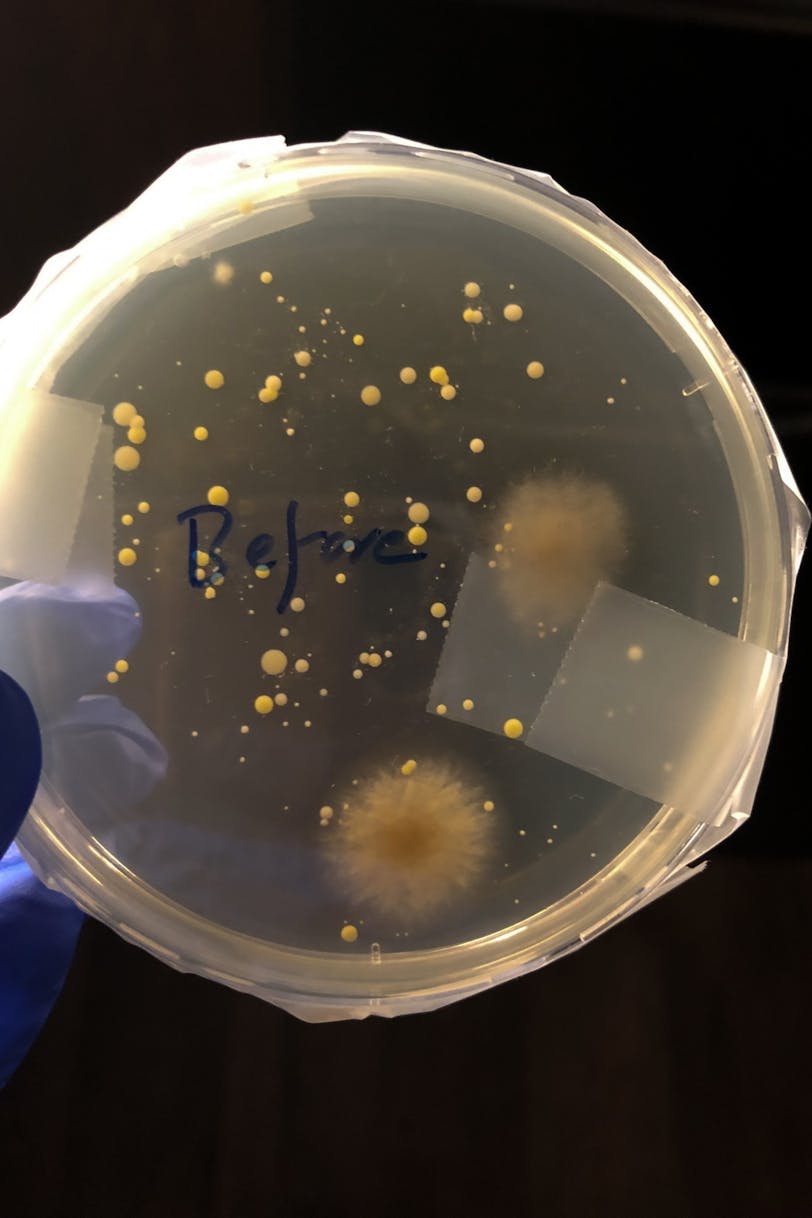
Biology 102 Microbial Group Assignment Unsanitized Hand.jpg

With nearly all classes conducted virtually this fall, students and professors who took part in lab courses this summer offer a preview into what labs will look like in a completely remote setting.
Students who took BIOL 101/102: Introduction to Biology A/B this summer were able to conduct hands-on labs such as fetal pig and sheep dissections from home by receiving the appropriate lab equipment and materials via mail. Students, however, said some labs were difficult to follow given the absence of immediate help and feedback from a teaching assistant who would typically oversee the labs in person.
TAs held synchronous Zoom sessions twice a week to explain how to perform the two labs assigned for that week, College sophomore Gaurav Gupta said. Students were able to perform the labs on their own time during the week.
Seven of the ten lab experiments in BIOL 101/102 this summer were conducted using mailed lab kits. The remaining labs were either conducted online, like the natural selection lab conducted on the interactive platform SimUText, or outside, like the biodiversity scavenger hunt where students identified organisms in their neighborhoods, BIOL 101/102 professor Linda Robinson said.

SimUText is a platform that creates virtual interactive real-world applicable labs.
Robinson had initially hoped to order lab kits from Carolina Biological, a supplier of science teaching materials based in North Carolina. Carolina Biological, however, was unable to supply the kits due to overwhelming demand from other schools, prompting the Biology department to put together a lab kit with reagents, dissection tools, pipets, culture dishes, personal protective equipment, and other lab materials sent to students via mail.
For the dissections, however, the Biology department was able to have Carolina Biological ship students a fetal pig and sheep organs prepared in shrink wrap in a box. Students were tasked to identify organs and describe the functions and relations of the organ systems, Robinson said.
Some students found the instructional videos of the dissections difficult to follow and were not always sure they were making the correct incisions or identifying organs correctly.
RELATED:
Here’s what the Ivy League is deciding for fall 2020
After reversal of fall plans, students demand Penn subsidize shipping costs for dorm items
“I feel like [the pig dissection videos] didn't do a great job of explaining exactly where everything was,” Gupta said. “I found it really difficult and a little bit annoying that they would show us this one video but then my specimen wouldn’t look exactly like that.”
Second-year Liberal and Professional Studies student Morgan Hawes added that the absence of a TA to answer questions and help during labs was a major drawback to the remote labs.
“There was a lack of guidance,” Hawes said. “It's like you're cutting open the pig, and you're like, 'I don't know if this is the right thing, or I don't know if this is the right way to do this.'”

Students who were enrolled in Biology 102 in the summer dissected a sheep eye as part of the summer laboratory experience.
Robinson acknowledged the challenge of conducting remote dissections without the live assistance of a TA.
“It's very difficult,” Robinson said. “You can't have a student doing a dissection in front of their Zoom lab session, and I can't have a TA helping every single student through their dissection.”
Gupta advised students taking lab courses in the fall to manage their time well, especially because remote labs are conducted on students' own time, and some labs might take longer than expected to complete.
“Never underestimate the amount of time that it will take you to do a lab,” Gupta said. “Give yourself enough time and make sure you do the labs as early as possible when they're assigned to you.”
Despite the difficulties of conducting a lab remotely, Hawes and Gupta said Robinson and the TAs did their best to maximize students' lab experience at home and offer some hands-on experiences. They added that the TAs' synchronous Zoom sessions and fast email communication helped make the remote lab experience easier.
“We actually got to do stuff like cut open animals and grow plants to actually do the lab, as opposed to just online exercises and simulations,” Hawes said.
An agar plate with colonies that grew from a test swab of an unwashed hand. The microbial experiment was one of a few experiments on which students collaborated.
The mailed lab kits, however, are not without an increased cost to the Biology department.
“There's definitely a cost associated with us not just ordering them, but the extra materials and … mailing [the] kits,” Robinson said.
The Biology department will provide students taking BIOL 101, BIOL 102, and BIOL 123: Introductory Molecular Biology Laboratory this fall with lab kits, which the department will order, package, and then ship to students.
Robinson added that the Biology department is currently working on how to provide lab kits for international students, as many countries do not allow these lab kits with chemical reagents to be shipped from overseas.
Robinson said she hopes the lab experience this fall will be more interactive than the summer. Instead of students performing the labs individually, she looks forward to students working in groups during synchronous Zoom sessions. In order to better cater to students' needs, TAs will be more flexible and offer a greater range of available office hours this fall, she added.
"Hopefully, [students] will look forward to enjoying biology lab and thinking of it as a way to escape all online learning and get to do some fun experiments on their own at home," Robinson said.










